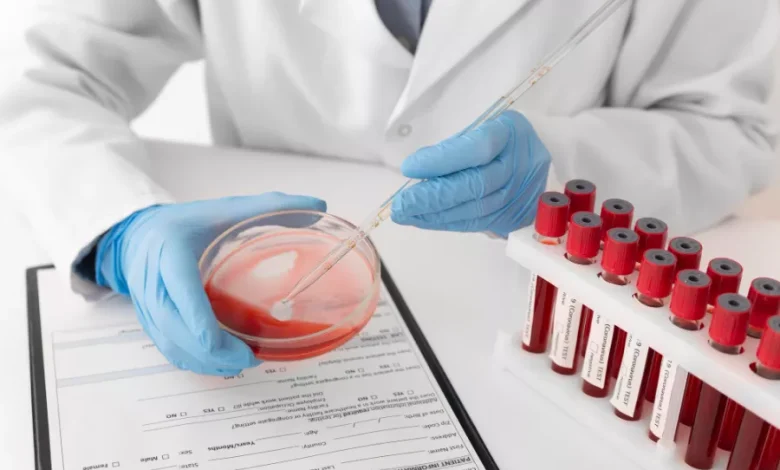

أسباب وأعراض نقص الصفائح الدموية.. والعلاجات
نقص الصفائح الدموية هو اضطراب مناعي يسبب النزيف، لأن للصفائح الدموية دوراً أساسياَ في التجلط ومنع النزيف. بشكل أوضح، الصفائح الدموية هي خلايا دم متخصصة تساعد في الحفاظ على سلامة جدران الأوعية الدموية، من ثم تساعد على منع النزيف إيقافه عن طريق تسريع عملية التجلط عند الحاجة.
يتراوح عدد الصفائح الدموية الطبيعي من حوالي 150.000 إلى 400.000 لكل ميكروليتر من الدم، لكن لا يحدث النزيف الذي يشكل خطراً إلا عندما يقل عدد الصفائح الدموية عن 50000 ميكرولتر.
تظهر مشكلة نقص الصفائح الدموية من خلال بعض الأعراض مثل النزيف تحت الجلد ما يسبب كدمات، أو نقاط حمراء صغيرة على الجلد تسمى النمشات. قد يظهر النزيف أيضاً داخل الأغشية المخاطية مثل الأنف والفم، وفي حالات نادرة في المعدة والجهاز الهضمي والمسالك البولية، ما يؤدي إلى انخفاض مستويات خلايا الدم الحمراء (فقر الدم) خاصة عند النساء اللاتي يعانين من دورات شهرية غزيرة جدًا.
نقص الصفائح الدموية.. ما هي الأعراض؟






